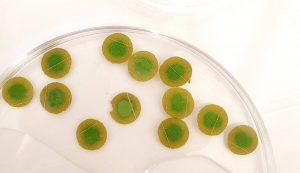

ozarkchinquapinmembership.org
Oxalic Acid Leaf Disc Assay
The fungal pathogen responsible for the blight,
Cryphonectria parasitica, secretes oxalic acid (oxalate) that kills healthy tissue and forms cankers on the bark of infected Ozark chinquapin trees. Oxalic acid assays can be used to rapidly screen for relative resistance based on the percent of living tissue remaining on leaf discs soaked in oxalic acid for a period of time. Because the leaf discs are uniform in size, living tissue can be quantified easily with image analysis software. This assay requires us to simply expose leaf tissue directly to oxalate and observe their tolerance.
 Blight Testing.
Blight Testing. Leaf discs soaking in 50 mM oxalic acid solution. The necrotic tissue is brown and the green leaf tissue is alive.
Chestnut blight is not a leaf disease, but a tree’s leaf tissue will have a reaction to oxalic acid exposure that correlates with the plant’s immune response and ability to detoxify oxalic acid (a mechanism apparently employed by trees with tolerance to chestnut blight). Leaf assay results from experiments where detached leaves were inoculated with agar plugs of blight correlate well with oxalic acid leaf disc assays
(Blight Resistance Testing 2019, 2021, and 2022, Leslie Bost Carter, OCF) . This technique for blight screening is especially useful on my trip to Arkansas considering its simplicity.
Methods
Several leaves from this year’s new growth were detached from each individual tree selected for screening, 21 total
(As detailed in the section about the second day of my trip). Leaves were also collected from 2 cultivated Chinese chestnut trees. The leaves were labeled, bagged, and placed in a cooler. All of the leaves were washed in 2 baths of distilled water and mild detergent, then gently blotted dry before the experiment. Leaf samples from 3 of the 21 trees I collected were damaged in transit and I excluded them from the study.
A sterile cork borer was used to punch out 10-12 leaf discs per sample set, then immediately placed into a petri dish containing a 50 mM oxalic acid solution. After soaking for 22 hours, photographs of the leaf discs were uploaded to plant disease quantification software (
Assess 2.0) and analyzed to calculate the exact percent of healthy tissue on each leaf disc
(Figure a). The average percent of living tissue remaining on the discs was recorded for each tree and plotted on a bar graph. Also, results for four of the six sites, were grouped and plotted on bar graphs for comparison.
Figure A. Screenshot of
Assess 2.0 image analysis software that calculates the percent of living tissue on the leaf discs using color thresholds to discriminate necrotic dead tissue (brown) from living tissue (green).
Blight Testing Results
The results of the leaf assay are presented in 2 graphs; the first (
fig 1) displays the relative blight resistance of all the trees screened and the second graph (
fig 2) displays the same information except it’s organized according to location on the the Mount Magazine Ranger District.
Leaf Assay Results
 Figure 1 . Blight Testing Results.
Figure 1 . Blight Testing Results. The graph displays the mean percent of living tissue for every trees screened on Mt Magazine. Trees with the greatest amount of living tissue remaining are most resistant to blight. The asterisk indicate trees with superior levels of blight tolerance and will be used as parent trees for breeding.
 Figure 2. Leaf Assay (Blight Testing) Results Displayed By Location On The Mountain
Figure 2. Leaf Assay (Blight Testing) Results Displayed By Location On The Mountain. I screened trees from 6 different sites on Mt Magazine Ranger District, and 4 of those sites (Greenbench, Northpointer, Major McLean, and Maggie) are displayed for comparison above. Sites on the mountain where less than 2 trees were tested per location are not shown, but you can find those trees represented in the combined graph in
figure 1.
The experiment results help characterize the disease susceptibility of the Ozark chinquapin in the area and we can see (
fig 1) that over 1/3 of the wild trees I screened had no living tissue after soaking in oxalic acid for 22 hours and are highly susceptible to the blight. The rest of the trees were moderately susceptible and a few had some natural genetic resistance. Keep in mind the superior trees I screened (ones that tested the best) were selected from wild populations 0f
hundreds and hundreds of trees on the mountain. The three trees with asterisks (fig 1) will be used as parent trees to develop seed with improved resistance by crossing them together and with other pure resistant Ozark chinquapin parent trees in the OCF’s breeding program.
When we look at the disease susceptibility of the trees according their location (
fig 2), the site we call “Northpointer” is unique because most of the trees there had at least some level of moderate tolerance to blight. The second most blight tolerant tree in the study was located in this group. Lingering remnant trees in this area could be at a slightly lower risk of complete elimination by the blight or it could be a group of more genetically robust trees. On the other hand, the site “Maggie” (where the former Arkansas state champion Ozark chinquapin was located) tested poorly and the small trees and little seedlings growing there today will most likely be eliminated by the blight within the next 15 years. The good news is we can recharge this area with blight resistant Ozark chinquapin and take advantage of the openings in the canopy created by dead chinquapin and replace them with a living tree.
The Ozark chinquapin tree has an important ecological role as a food source for wildlife and when the trees started disappearing they were replaced by oaks and other species that don’t provide the same nutritional value and consistency. The work we’re doing to return Ozark chinquapin on Mount Magazine is a conservation triumph, not just for the tree, but for the various animals and insects who benefit from them.